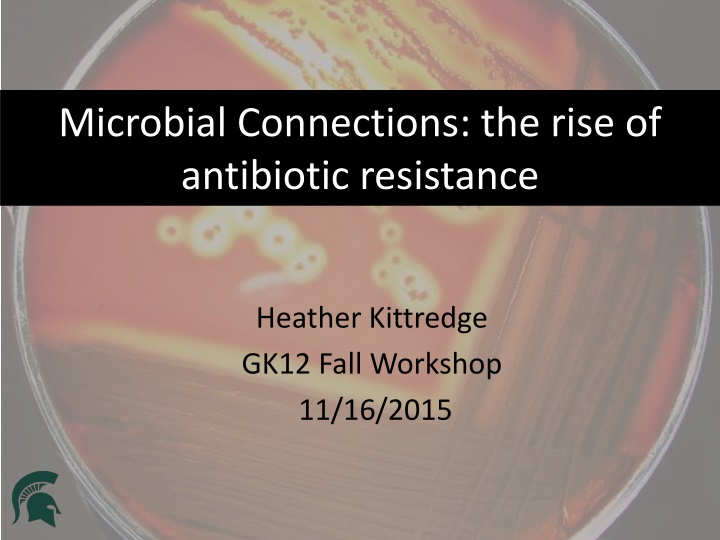

Antibiotic Resistance: A Comprehensive Overview
Explore the world of antibiotic resistance through a journey that covers the basics, historical developments, mechanisms, consequences, and current challenges. From the first antibiotic discovery to the impact of overuse, this overview delves into the crucial topic of microbial connections and the rise of antibiotic resistance. Discover the classes of antibiotics, their usage, and the urgent need to address this growing concern in our fight against bacterial infections.
Download Presentation

Please find below an Image/Link to download the presentation.
The content on the website is provided AS IS for your information and personal use only. It may not be sold, licensed, or shared on other websites without obtaining consent from the author.If you encounter any issues during the download, it is possible that the publisher has removed the file from their server.
You are allowed to download the files provided on this website for personal or commercial use, subject to the condition that they are used lawfully. All files are the property of their respective owners.
The content on the website is provided AS IS for your information and personal use only. It may not be sold, licensed, or shared on other websites without obtaining consent from the author.
E N D
Presentation Transcript
Microbial Connections: the rise of antibiotic resistance Heather Kittredge GK12 Fall Workshop 11/16/2015
Talk Outline Introduction to antibiotic resistance The antibiotic resistance crisis Next steps
Bacterial Warfare Bacteria must compete with each other to survive. One bacterial defense is to secrete toxins! Antibiotics are these same toxins produced in mass quantities to kill bacteria that harm mammalian cells.
The First Antibiotic Penicillium The first antibiotic was discovered by Alexander Fleming in 1928 when he noticed that the fungus penicillium killed disease causing bacteria.
Antibiotics target bacteria Zone of Inhibition
Antibiotic Resistance Facts Antibiotic resistance is the process by which bacteria become resistant to antibiotics. Humans can have allergic reactions to antibiotics, but we do not become resistant to antibiotics.
Antibiotic Classes Tetracyclines Tetracycline(Sumycin) doxycycline (Vibramycin) Aminoglycosides gentamicin (Garamycin) kanamycin tobramycin(Tobrex) Macrolides erythromycin (E-Mycin) azithromycin (Zithromax) Penicillins penicillin amoxicillin Cephalosporins cephalexin(Keflex) Sulfonamides co-trimoxazole (Bactrim) Fluoroquinolones ciprofolxacin (Cipro) levofloxacin (Levaquin) ofloxacin (Floxin) Prevents bacteria from making cell walls Inhibits Folate synthesis Inhibits DNA replication Inhibits protein synthesis
Antibiotic Usage Transplants Dialysis Suppressed Immune Systems Joint Replacements
Antibiotic Overuse 1. Overprescribing 2. Continuous use in livestock feed Humans = 30% antibiotic use Animals = 70% https://amr-review.org/file/327
How does antibiotic resistance arise? Dose Two of Dose One of Antibiotics Antibiotics
Resistance is an evolutionary process Mechanisms of Evolutionary Change: 1. Mutation 2. Natural Selection 3. Gene Flow 4. Genetic Drift Destroys RNA polymerase A single base pair mutation in the gene rpoB confers resistance to rifampicin.
Antibiotic resistance crisis An increase in resistant organisms + A limited number of new antimicrobial drugs = a problematic scenario The pharmaceutical industry has largely turned away from antibiotic research due to the low likelihood of getting a return on investment. Any new class of antibiotics would need to be used sparingly to conserve their effectiveness, meaning sales would be slow. - WSJ
Post-antibiotic era Currently: - 80% of gonorrhoeal infections are now resistant to antibiotics. - 440,000 new cases of drug-resistant tuberculosis annually. In the future: - Strep throat to a scraped knee could kill you. - A simple hip replacement would result in 1 and 6 deaths. - The cost to treat drug-resistant cases is estimated to be at least double. Antibiotic resistance should be added to the list of national emergencies . Sally Davies (Britain s Chief Medical Officer)
The Davos Declaration International pharmaceutical, diagnostics and biotechnology companies, as well as key industry bodies, have come together to work in parallel in taking comprehensive action against drug-resistant infections . 1. Reducing the development of drug resistance. 2. Increasing investment in R&D that meets global public health needs. 3. Improve access to high-quality antibiotics for all.
Discovering Antibiotics in New Ways Teixobactin: A new class of antibiotics iChip In the Nature study, teixobactin was shown to kill Staphylococcus aureus and Mycobacterium tuberculosis without the bacteria developing a resistance to the antibiotic. Binds to lipids that build the cell wall.
Modeling Antibiotic Resistance with Candy Bacteria targeted by antibiotic Antibiotic Bacteria resistant to antibiotic